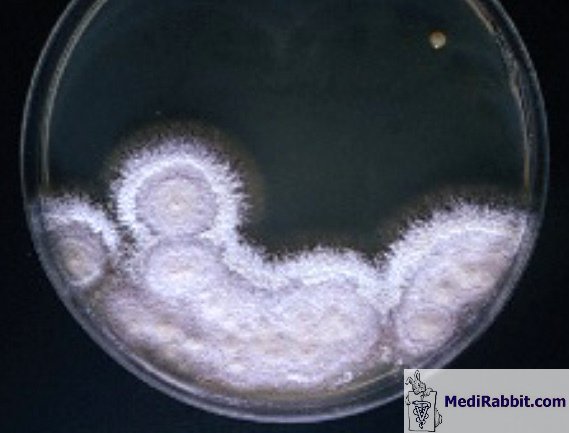

Dermatose
fongique ou teigne chez le lapin
Esther van Praag, Ph.D.
|
MediRabbit.com est
financé uniquement par la générosité de donateurs. Chaque don, peu importe la somme, représente maroonune
contribution considérable et aidera à la poursuite de la recherche sur les
maladies, les soins, et la santé des lapins. Merci |
Attention: cette page peut
contenir des images qui peuvent être pénibles pour certaines personnes.
Les mycoses ne sont pas
communes chez les lapins sauvages et domestiques et elles se rencontrent
rarement sous forme épidémique. Elles se rencontrent plutôt comme des
infections sporadiques sur un lapin individuel, des jeunes ou un lapin
malade, dont le système immunitaire est affaibli.
Deux champignons
pathogènes sont à l’origine de ce problème:
- Trichophyton mentagrophytes
= teigne tonsurante.
Peut être présent de
façon asymptomatique dans la fourrure du lapin.
- Microsporum canis.
Infeste
occasionnellement les lapins via le contact avec des chiens ou des chats. Ce
champignon possède un potentiel zoonotique, et se transmet aux êtres humains.
La teigne est la cause
principale des mycoses chez le lapin. Elle infeste non seulement l’épiderme,
mais aussi les structures annexes, tels les follicules pileux et le poil.
Dans certains cas, la culture des tissus infestés a démontré la présence de Microsporum sp.
Signes cliniques
Les mycoses sont
typiquement observées autour de la tête, mais se propagent vers les membres,
les pieds et les doigts de pieds. Les lésions sont enflammées, circonscrites
et érythémateuses, avec de petites croûtes sèches qui peuvent démanger et une alopécie
circonscrite. Le tissu sous les croûtes est enflammé et des infections
bactériennes secondaires se développent parfois dans les follicules pileux.
Un examen histologique
révèle généralement une hyperkératose, une folliculite, une acanthose et une infiltration diffuse de leucocytes à
travers les couches du derme.
Diagnostic
1. Cultures sur un milieu pour champignons
ou dermatophytes. Les résultats obtenus ne sont pas toujours fiables et
doivent être complétés par une étude histologique.
2. Identification des spores dans les échantillons
de peau obtenus par raclage et dissous dans du KOH 10%.
3. Fluorescence (lumière UV) n’est pas
toujours utile. Un champignon (Trichophyton mentagrophytes)
ne fluoresce pas, tandis que certaines souches de Microsporum
canis fluorescencent,
d’autres pas.
4. Coloration Gomori methenamine argent,
coloration pour champignon Gridley et acide
périodique de Schiff
(PAS) permettent de démontrer la présence d’arthrospores et de les
identifier.
Le
diagnostic doit différencier la mycose des autres causes d’alopécie observé
au niveau de la tête et des oreilles (alopécie génétique, traumatisme,
arrachage de poils).
Traitement
Les poils autour des
lésions doivent être tondus et, si possible, détruit par le feu. Le meilleur
traitement contre les mycoses cutanées et l’administration orale de
griseofulvine (25-50 mg/kg PO q24h ou divisé q12h). (Porter des gants lors de
l’administration du médicament. Le traitement dure jusqu’à 2 semaines au-delà
de la disparition des signes cliniques.
Un traitement local est
également possible, avec des crèmes antifongiques:
• Clotrimazole
cream or lotion;
• Enilconazole
spray;
• Itraconazole (5-10 mg/PO, q 24 h);
• Terbinafine (8-20 mg/kg PO, q24h);
• Ketoconazole (10-15 mg/kg PO q 24h) (not
to be used in breeding animals);
• Miconazole
(crème).
La plupart des produits
mentionnés ne sont pas licenciés pour usage chez le lapin ; des articles
scientifiques montrent pourtant que ces produits ont été employés avec succès
dans le traitement des mycoses chez le lapin.
L’environnement
du lapin doit être soigneusement nettoyé: aspirateur, laver le matériel en
tissu à 95°C et nettoyer les surfaces avec de l’eau de Javel 1:10.
Remerciement
Un grand merci à Lynne Huntley (USA),
au Dr. Katleen Hermans (Kliniek
voor Pluimvee en Bijzondere Dieren Universiteit Gent, Belgique), à Michel Gruaz (Suisse) et au Prof. Richard Hoop (Institut für Veterinärbakteriologie, University of Zurich, Suisse) pour leurs photos.
Information
supplémentaire
K. L. Banks, T. B. Clarckson
(1967) Naturally occurring dermatomycosis in the
rabbit. J. Am. Med. Assoc. 151: 926-29.
K. W. Hagen (1969) Ringworm in domestic rabbits:
Oral treatment with griseofulvin. Lab Anim. Care
19: 635-638.
E. V. Hillyer, K. Quesenberry, S. Valkoff (1997)
Ferrets, Rabbits and Rodents: Clinical Medicine and Surgery, (Editor)
Saunders W B Co, p. 215.
L. M. Vogstberger et al. (1986) Spontaneous dermatomycosis due
to Microsporum canis
in rabbits. Lab. Anim. Sci. 36: 294-97.
|
|||||||||||||||||
e-mail: info@medirabbit.com